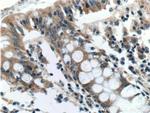
AOAH Antibody in Immunohistochemistry (Paraffin) (IHC (P))

Search
Proteintech
AOAH Polyclonal Antibody
{{$productOrderCtrl.translations['antibody.pdp.commerceCard.promotion.promotions']}}
{{$productOrderCtrl.translations['antibody.pdp.commerceCard.promotion.viewpromo']}}
{{$productOrderCtrl.translations['antibody.pdp.commerceCard.promotion.promocode']}}: {{promo.promoCode}} {{promo.promoTitle}} {{promo.promoDescription}}. {{$productOrderCtrl.translations['antibody.pdp.commerceCard.promotion.learnmore']}}
产品信息
12911-1-AP
种属反应
宿主/亚型
分类
类型
抗原
偶联物
形式
浓度
规格
纯化类型
保存液
内含物
保存条件
运输条件
产品详细信息
Immunogen sequence: QDSNCNGIW GVDPKDGVPY EKKFCEGSQP RGIILLGDSA GAHFHISPEW ITASQMSLNS FINLPTALTN ELDWPQLSGA TGFLDSTVGI KEKSIYLRLW KRNHCNHRDY QNISRNGASS RNLKKFIESL SRNKVLDYPA IVIYAMIGND VCSGKSDPVP AMTTPEKLYS NVMQTLKHLN SHLPNGSHVI LYGLPDGTFL WDNLHNRYHP LGQLNKDMTY AQLYSFLNCL QVSPCHGWMS SNKTLRTLTS ERAEQLSNTL KKIAASEKFT NFNLFYMDFA FHEIIQEWQK RGGQPWQLIE PVDGFHPNEV ALLLLADHFW KKVQLQWPQI LGKENPFNPQ IKQVFGDQGG H (226-575 aa encoded by BC025698)
靶标信息
Removes the secondary (acyloxyacyl-linked) fatty acyl chains from the lipid A region of bacterial lipopolysaccharides.
仅用于科研。不用于诊断过程。未经明确授权不得转售。
生物信息学
蛋白别名: Acyloxyacyl hydrolase; acyloxyacyl hydrolase (neutrophil); unnamed protein product
基因别名: 4930433E13Rik; AOAH; RGD1560514
UniProt ID: (Human) P28039, (Mouse) O35298
Entrez Gene ID: (Human) 313, (Rat) 498757, (Mouse) 27052